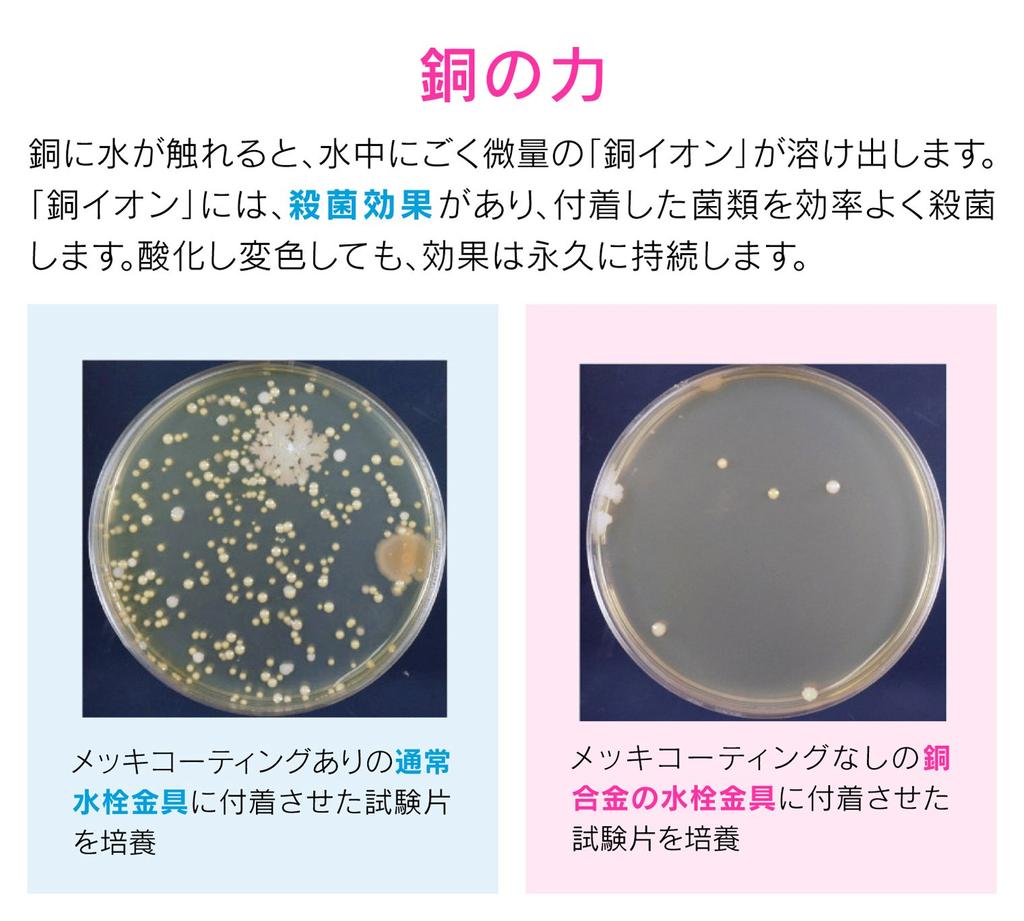

Svetainė nepalaiko jūsų naršyklės. Atnaujinkite naršyklę arba atsisiųskite kitą
Gaona Sink Drain Garbage Disposal 8cm Antibacterial Copper Cover Garbage Disposal Rental Mini Kitchen GA-PB045
Dabartinė kaina
Kaina 83,86 €su PVM

Pristatymas 11‑32 darbo dienas

Pristatymas € 5
Gražinimo sąlygos
Saugūs mokėjimai









Palaikymo tarnyba šneka rusų kalba
Safety & compliance
Aprašymas
nicoplace
5/8
Panašios prekės